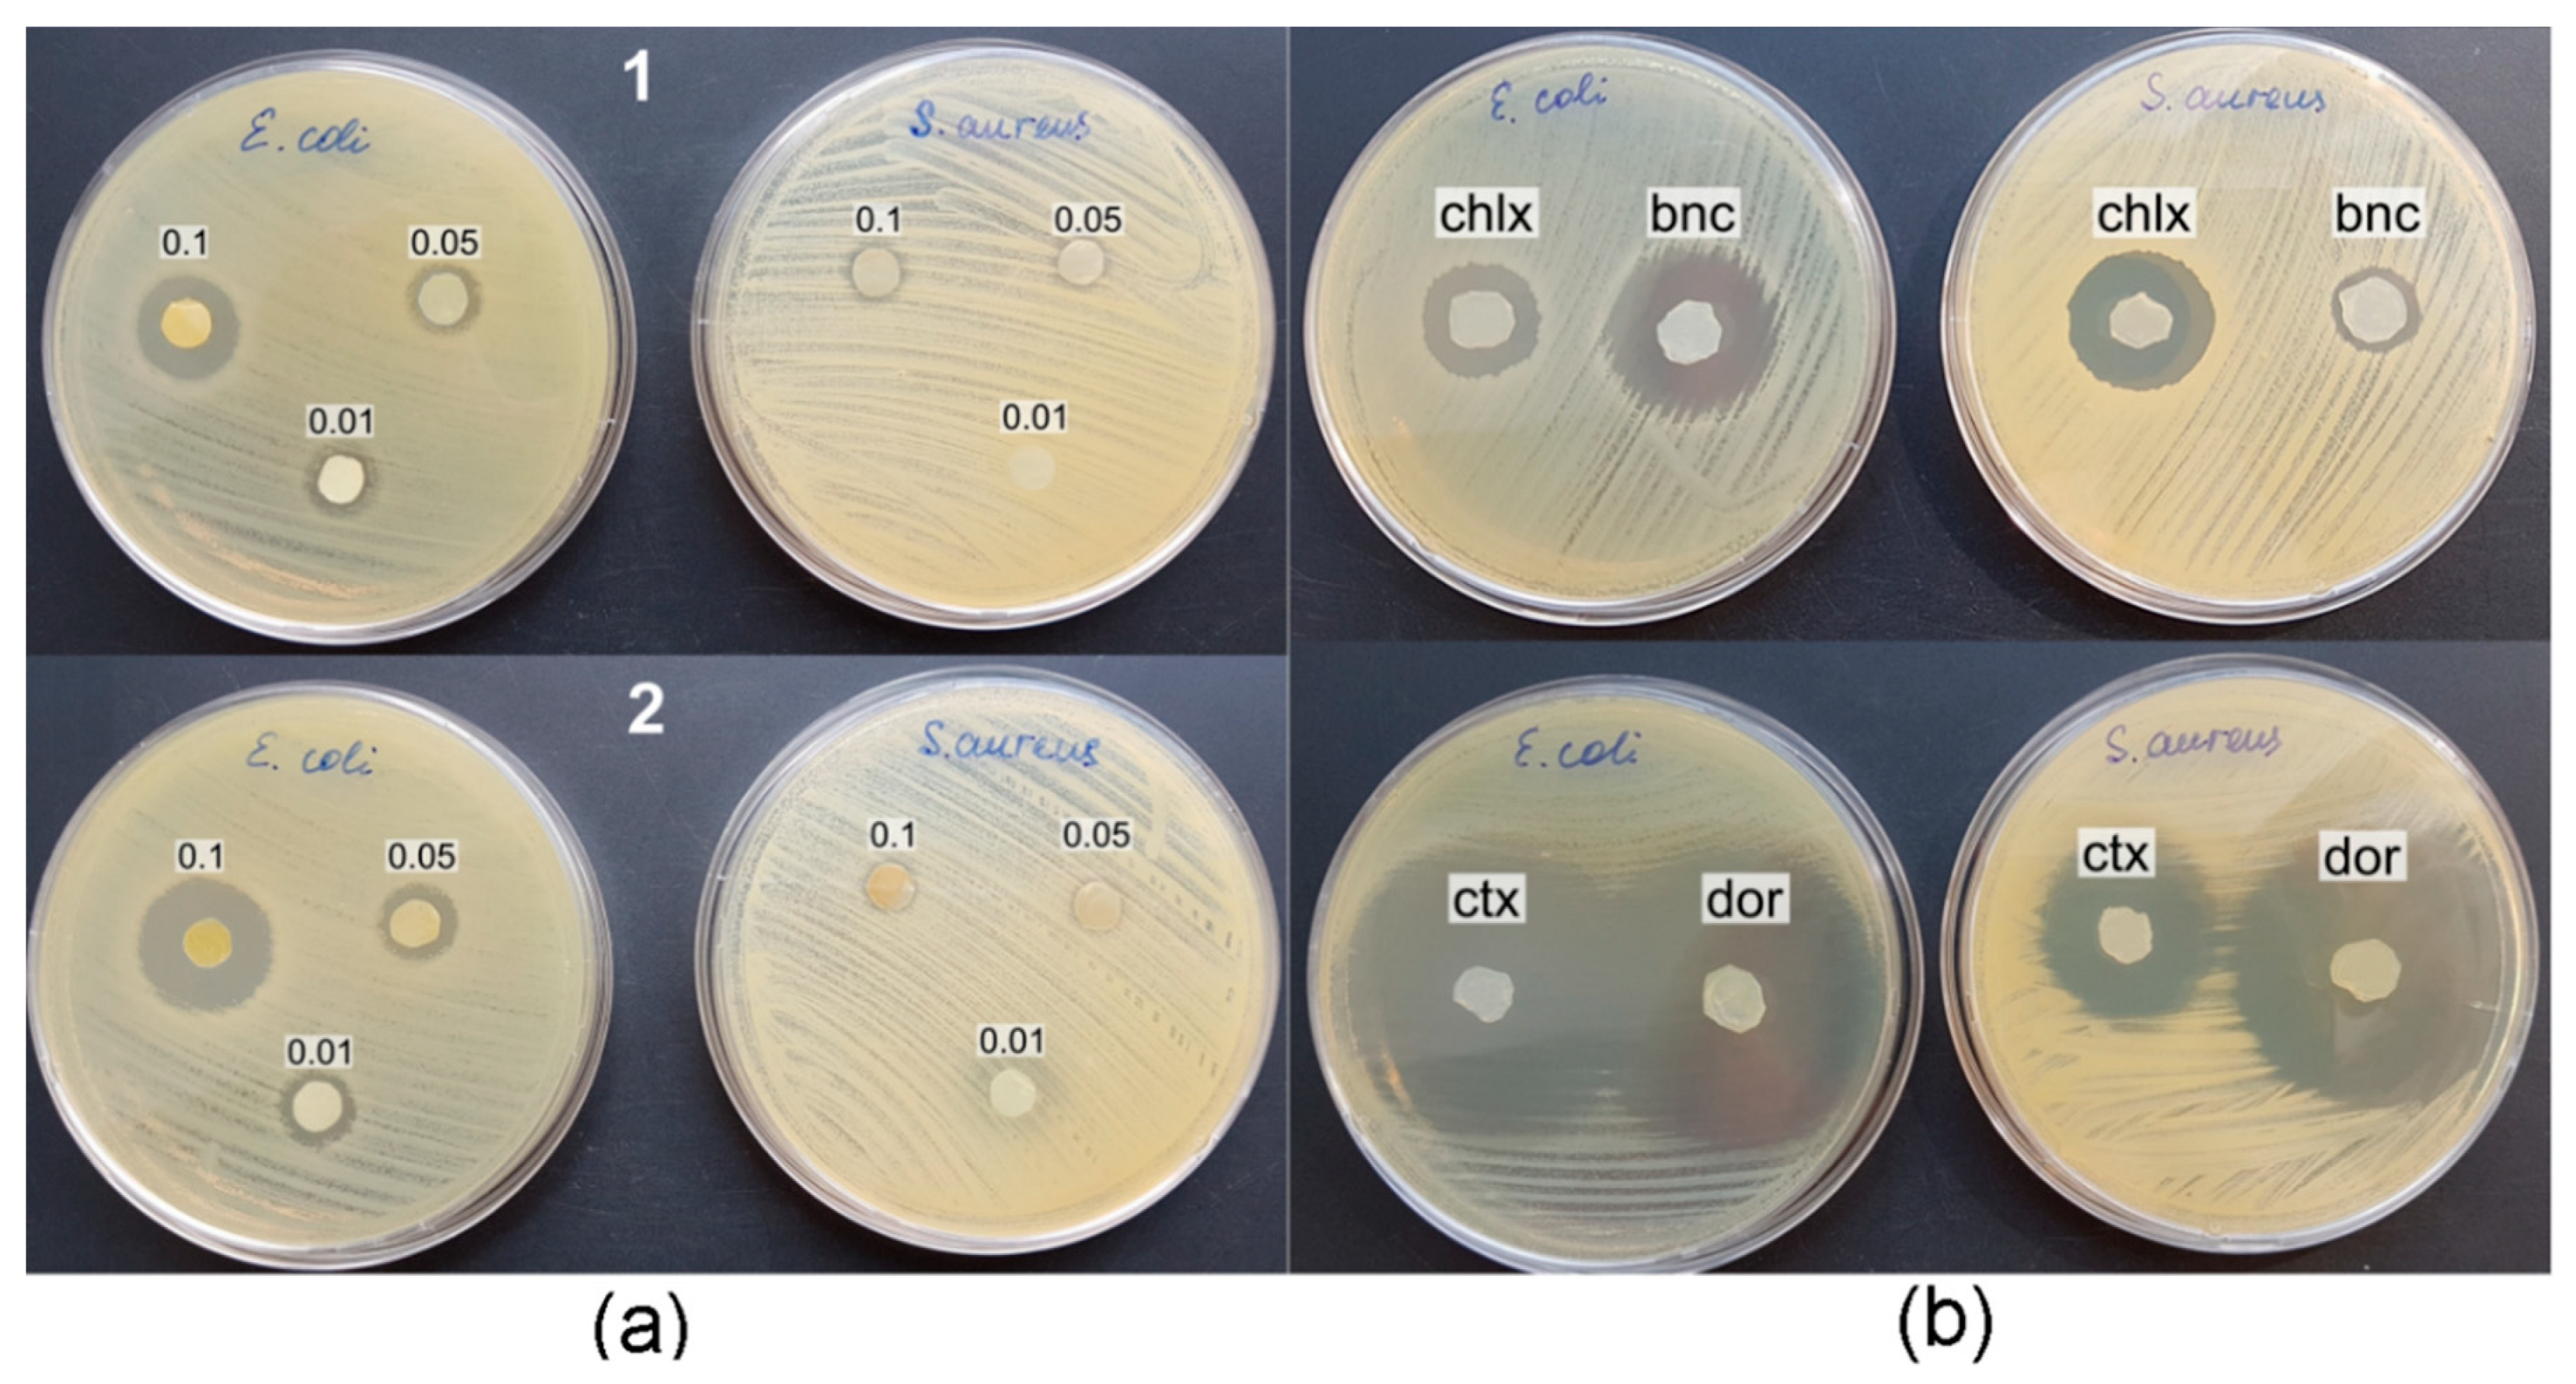
Nanomaterials 12 00192 g010

Bacterial Cellulose (BC) and BC Composites: Production and Properties
Abstract
:1. Introduction
2. Materials and Methods
2.1. Production of Bacterial Cellulose
2.2. Production of Bacterial Cellulose Composites
2.3. A Study of Microstructure, Physicochemical, and Mechanical Properties of Bacterial Cellulose Composites
2.4. In Vitro Antibacterial Tests
2.5. Statistical Analysis
3. Results and Discussion
3.1. Production Characteristics of the K. xylinus B-12068 Strain Grown on Various C-Substrates
3.2. Structure and Properties of BC Synthesized by K. xylinus B-12068
3.3. Preparation and Characterization of BC Composites with Nanosilver and Antimicrobial Drugs
3.4. Antibacterial Properties of BC Composites
4. Conclusions
Author Contributions
Funding
Institutional Review Board Statement
Informed Consent Statement
Data Availability Statement
Acknowledgments
Conflicts of Interest
References
- Saxena, I.M.; Brown, R.M., Jr. Biosynthesis of Bacterial Cellulose. In Bacterial Nanocellulose: A Sophisticated Multifunctional Material; Gama, M., Gatenholm, P., Klemm, D., Eds.; CRC Press: Boca Raton, FL, USA, 2012; pp. 1–18. ISBN 978-1-4398-6991-8. [Google Scholar]
- Zhao, Y.; Li, J. Excellent chemical and material cellulose from tunicates: Diversity in cellulose production yield and chemical and morphological structures from different tunicate species. Cellulose 2014, 21, 3427–3441. [Google Scholar] [CrossRef]
- Klemm, D.; Heublein, B.; Fink, H.P.; Bohn, A. Cellulose: Fascinating biopolymer and sustainable raw material. Angew. Chem. Int. Ed. Engl. 2005, 44, 3358–3393. [Google Scholar] [CrossRef]
- Shoda, M.; Sugano, Y. Recent advances in bacterial cellulose production. Biotechnol. Bioprocess Eng. 2005, 10, 1. [Google Scholar] [CrossRef]
- Khan, T.; Park, J.K.; Kwon, J.-H. Functional biopolymers produced by biochemical technology considering applications in food engineering. Korean J. Chem. Eng. 2007, 24, 816–826. [Google Scholar] [CrossRef]
- Shezad, O.; Khan, S.; Khan, T.; Park, J.K. Physicochemical and mechanical characterization of bacterial cellulose produced with an excellent productivity in static conditions using a simple fed-batch cultivation strategy. Carbohydr. Polym. 2010, 82, 173–180. [Google Scholar] [CrossRef]
- Yamada, Y. Transfer of Gluconacetobacter kakiaceti, Gluconacetobacter medellinensis and Gluconacetobacter maltaceti to the genus Komagataeibacter as Komagataeibacter kakiaceti comb. nov., Komagataeibacter medellinensis comb. nov. and Komagataeibacter maltaceti comb. nov. Int. J. Syst. Evol. Microbiol. 2014, 64, 1670–1672. [Google Scholar] [CrossRef] [PubMed]
- Matsutani, M.; Ito, K.; Azuma, Y.; Ogino, H.; Shirai, M.; Yakushi, T.; Matsushita, K. Adaptive mutation related to cellulose producibility in Komagataeibacter medellinensis (Gluconacetobacter xylinus) NBRC 3288. Appl. Microbiol. Biotechnol. 2015, 99, 7229–7240. [Google Scholar] [CrossRef] [PubMed]
- Kadier, A.; Ilyas, R.A.; Huzaifah, M.R.M.; Harihastuti, N.; Sapuan, S.M.; Harussani, M.M.; Azlin, M.N.M.; Yuliasni, R.; Ibrahim, R.; Atikah, M.S.N.; et al. Use of industrial wastes as sustainable nutrient sources for bacterial cellulose (BC) production: Mechanism, advances, and future perspectives. Polymers 2021, 13, 3365. [Google Scholar] [CrossRef] [PubMed]
- Omran, A.A.B.; Mohammed, A.A.B.A.; Sapuan, S.M.; Ilyas, R.A.; Asyraf, M.R.M.; Rahimian Koloor, S.S.; Petrů, M. Micro- and nanocellulose in polymer composite materials: A review. Polymers 2021, 13, 231. [Google Scholar] [CrossRef] [PubMed]
- Abral, H.; Chairani, M.K.; Rizki, M.D.; Mahardika, M.; Handayani, D.; Sugiarti, E.; Muslimin, A.N.; Sapuan, S.M.; Ilyas, R.A. Characterization of compressed bacterial cellulose nanopaper film after exposure to dry and humid conditions. J. Mater. Res. Technol. 2021, 11, 896–904. [Google Scholar] [CrossRef]
- Abral, H.; Pratama, A.B.; Handayani, D.; Mahardika, M.; Aminah, I.; Sandrawati, N.; Sugiarti, E.; Muslimin, A.N.; Sapuan, S.M.; Ilyas, R.A. Antimicrobial edible film prepared from bacterial cellulose nanofibers/starch/chitosan for a food packaging alternative. Int. J. Polym. Sci. 2021, 2021, 6641284. [Google Scholar] [CrossRef]
- Petersen, N.; Gatenholm, P. Bacterial cellulose-based materials and medical devices: Current state and perspectives. Appl. Microbiol. Biotechnol. 2011, 91, 1277–1286. [Google Scholar] [CrossRef]
- Lin, W.C.; Lien, C.C.; Yeh, H.J.; Yu, C.M.; Hsu, S.H. Bacterial cellulose and bacterial cellulose chitosan membranes for wound dressing applications. Carbohydr. Polym. 2013, 94, 603–611. [Google Scholar] [CrossRef] [PubMed]
- Lin, S.P.; Calvar, I.L.; Catchmark, J.M.; Liu, J.R.; Demirci, A.; Cheng, K.C. Biosynthesis, production and applications of bacterial cellulose. Cellulose 2013, 20, 2191–2219. [Google Scholar] [CrossRef]
- Lee, K.Y.; Buldum, G.; Mantalaris, A.; Bismarck, A. More than meets the eye in bacterial cellulose: Biosynthesis, bioprocessing, and applications in advanced fiber composites. Macromol. Biosci. 2014, 14, 10–32. [Google Scholar] [CrossRef] [PubMed] [Green Version]
- Lee, J.W.; Deng, F.; Yeomans, W.G.; Allen, A.L.; Gross, R.A.; Kaplan, D.L. Direct incorporation of glucosamine and N-acetylglucosamine into exopolymers by Gluconacetobacter xylinus (Acetobacter xylinum) ATCC 10245: Production of chitosan-cellulose and chitin-cellulose exopolymers. Appl. Environ. Microbiol. 2001, 67, 3970–3975. [Google Scholar] [CrossRef] [Green Version]
- Yadav, V.; Paniliatis, B.J.; Shi, H.; Lee, K.; Cebe, P.; Kaplan, D.L. Novel in vivo-degradable cellulose-chitin copolymer from metabolically engineered Gluconacetobacter xylinus. Appl. Environ. Microbiol. 2010, 76, 6257–6265. [Google Scholar] [CrossRef] [Green Version]
- Chawla, P.R.; Bajaj, I.B.; Survase, S.A.; Singhal, R.S. Microbial cellulose: Fermentative production and applications. Food Technol. Biotechnol. 2009, 47, 107–124. [Google Scholar]
- Svensson, A.; Nicklasson, E.; Harrah, T.; Panilaitis, B.; Kaplan, D.; Brittberg, M. Bacterial cellulose as a potential scaffold for tissue engineering of cartilage. Biomaterials 2005, 26, 419–431. [Google Scholar] [CrossRef]
- Yano, H.; Sugiyama, J.; Nakagaito, A.N.; Nogi, M.; Matsuura, T.; Hikita, M. Optically transparent composites reinforced with networks of bacterial nanofibers. Adv. Mater. 2005, 17, 153–155. [Google Scholar] [CrossRef]
- Beekmann, U.; Zahel, P.; Karl, B.; Schmölz, L.; Börner, F.; Gerstmeier, J.; Werz, O.; Lorkowski, S.; Wiegand, C.; Fischer, D.; et al. Modified bacterial cellulose dressings to treat inflammatory wounds. Nanomaterials 2020, 10, 2508. [Google Scholar] [CrossRef] [PubMed]
- Frone, A.N.; Panaitescu, D.M.; Nicolae, C.A.; Gabor, A.R.; Trusca, R.; Casarica, A.; Stanescu, P.O.; Baciu, D.D.; Salageanu, A. Bacterial cellulose sponges obtained with green cross-linkers for tissue engineering. Mater. Sci. Eng. C 2020, 110, 110740. [Google Scholar] [CrossRef] [PubMed]
- Nimeskern, L.; Avila, H.M.; Sundberg, J.; Gatenholm, P.; Müller, R.; Stok, K.S. Mechanical evaluation of bacterial nanocellulose as an implant material for ear cartilage replacement. J. Mech. Behav. Biomed. Mater. 2013, 22, 12–21. [Google Scholar] [CrossRef] [PubMed] [Green Version]
- Millon, L.; Wan, W. The polyvinyl alcohol-bacterial cellulose system as a new nanocomposite for biomedical applications. J. Biomed. Mater. Res. B. Appl. Biomater. 2006, 79, 245–253. [Google Scholar] [CrossRef] [PubMed]
- Klemm, D.; Schumann, D.; Udhardt, U.; Marsch, S. Bacterial synthesized cellulose—Artificial blood vessels for microsurgery. Prog. Polym. Sci. 2001, 26, 1561–1603. [Google Scholar] [CrossRef]
- Wan, Y.; Gao, C.; Han, M.; Liang, H.; Ren, K.; Wang, Y. Preparation and characterization of bacterial cellulose/heparin hybrid nanofiber for potential vascular tissue engineering scaffolds. Polym. Adv. Technol. 2011, 22, 2643–2648. [Google Scholar] [CrossRef]
- Wang, J.; Gao, C.; Zhang, Y.; Wan, Y. Preparation and in vitro characterization of BC/PVA hydrogel composite for its potential use as artificial cornea biomaterial. Mater. Sci. Eng. C. 2010, 30, 214–218. [Google Scholar] [CrossRef]
- Yoshino, A.; Tabuchi, M.; Uo, M.; Tatsumi, H.; Hideshima, K.; Kondo, S. Applicability of bacterial cellulose as an alternative to paper points in endodontic treatment. Acta Biomater. 2013, 9, 6116–6122. [Google Scholar] [CrossRef]
- Fu, L.; Zhang, J.; Yang, G. Present status and applications of bacterial cellulose-based materials for skin tissue repair. Carbohydr. Polym. 2013, 92, 1432–1442. [Google Scholar] [CrossRef]
- Coffindaffer, T.W.; Heath, B.P.; Kyte, K.E.; McConaughy, S.D.; Smith, E.D. Personal Cleansing Compositions Comprising a Bacterial Cellulose Network and Cationic Polymer. U.S. Patent 8,097,574, 17 January 2012. [Google Scholar]
- Hasan, N.; Biak, D.R.A.; Kamarudin, S. Application of bacterial cellulose (BC) in natural facial scrub. Int. J. Adv. Sci. Eng. Inform. Technol. 2012, 2, 272–275. [Google Scholar] [CrossRef] [Green Version]
- Amnuaikit, T.; Chusuit, T.; Raknam, P.; Boonme, P. Effects of a cellulose mask synthesized by a bacterium on facial skin characteristics and user satisfaction. Med. Dev. 2011, 4, 77–81. [Google Scholar] [CrossRef] [Green Version]
- Swingler, S.; Gupta, A.; Gibson, H.; Kowalczuk, M.; Heaselgrave, W.; Radecka, I. Recent advances and applications of bacterial cellulose in biomedicine. Polymers 2021, 13, 412. [Google Scholar] [CrossRef] [PubMed]
- Fink, H.; Hong, J.; Drotz, K.; Risberg, B.; Sanchez, J.; Sellborn, A. An in vitro study of blood compatibility of vascular grafts made of bacterial cellulose in comparison with conventionally-used graft materials. J. Biomed. Mater. Res. A 2011, 97, 52–58. [Google Scholar] [CrossRef] [PubMed]
- Leitao, A.F.; Gupta, S.; Silva, J.P.; Reviakine, I.; Gama, M. Hemocompatibility study of a bacterial cellulose/polyvinyl alcohol nanocomposite. Colloids Surf. B Biointerfaces 2013, 111, 493–502. [Google Scholar] [CrossRef] [Green Version]
- Shah, N.; Ul-Islam, M.; Khattak, W.A.; Park, J.K. Overview of bacterial cellulose composites: A multipurpose advanced material. Carbohydr. Polym. 2013, 98, 1585–1598. [Google Scholar] [CrossRef] [PubMed]
- Torres, F.G.; Commeaux, S.; Troncoso, O.P. Biocompatibility of bacterial cellulose based biomaterials. J. Funct. Biomater. 2012, 3, 864–878. [Google Scholar] [CrossRef] [Green Version]
- Culebras, M.; Grande, C.J.; Torres, F.G.; Troncoso, O.P.; Gomez, C.M.; Bañó, M.C. Optimization of cell growth on bacterial cellulose by adsorption of collagen and poly-L-lysine. Int. J. Polym. Mater. Polym. Biomater. 2015, 64, 411–415. [Google Scholar] [CrossRef]
- Dobre, M.L.; Stoica-Guzun, A. Antimicrobial Ag-polyvinyl alcohol-bacterial cellulose composite films. J. Biobased Mater. Bioenergy 2013, 7, 157–162. [Google Scholar] [CrossRef]
- Kwak, H.; Kim, J.E.; Go, J.; Koh, E.K.; Song, S.H.; Son, H.J.; Kim, H.S.; Yun, Y.H.; Jung, Y.J.; Hwang, D.Y. Bacterial cellulose membrane produced by Acetobacter sp. A10 for burn wound dressing applications. Carbohydr. Polym. 2015, 122, 387–398. [Google Scholar] [CrossRef]
- Chang, W.S.; Chen, H.H. Physical properties of bacterial cellulose composites for wound dressings. Food Hydrocoll. 2016, 53, 75–83. [Google Scholar] [CrossRef]
- Ullah, H.; Wahid, F.; Santos, H.A.; Khan, T. Advances in biomedical and pharmaceutical applications of functional bacterial cellulose-based nanocomposites. Carbohydr. Polym. 2016, 150, 330–352. [Google Scholar] [CrossRef] [PubMed]
- Long, W.; Ouyang, H.; Hu, X.; Liu, M.; Zhang, X.; Feng, Y.; Wei, Y. State-of-art review on preparation, surface functionalization and biomedical applications of cellulose nanocrystals-based materials. Int. J. Biol. Macromol. 2021, 186, 591–615. [Google Scholar] [CrossRef] [PubMed]
- Czaja, W.K.; Young, D.J.; Kawecki, M.; Brown, R.M. The future prospects of microbial cellulose in biomedical applications. Biomacromolecules 2007, 8, 1–12. [Google Scholar] [CrossRef]
- Barud, H.G.O.; da Silva, R.R.; Barud, H.S.; Tercjak, A.; Gutierrez, J.; Lustri, W.R.; Oliveira, O.B., Jr.; Ribeiro, S.J.L. A multipurpose natural and renewable polymer in medical applications: Bacterial cellulose. Carbohydr. Polym. 2016, 153, 406–420. [Google Scholar] [CrossRef] [Green Version]
- Cielecka, I.; Szustak, M.; Gendaszewska-Darmach, E.; Kalinowska, H.; Ryngajłło, M.; Maniukiewicz, W.; Bielecki, S. Novel bionanocellulose/κ-carrageenan composites for tissue engineering. Appl. Sci. 2018, 8, 1352. [Google Scholar] [CrossRef] [Green Version]
- Abeer, M.M.; Mohd Amin, M.C.I.; Martin, C. A review of bacterial cellulose-based drug delivery systems: Their biochemistry, current approaches and future prospects. J. Pharm. Pharmacol. 2014, 66, 1047–1061. [Google Scholar] [CrossRef] [PubMed]
- Lunardi, V.B.; Soetaredjo, F.E.; Putro, J.N.; Santoso, S.P.; Yuliana, M.; Sunarso, J.; Ju, Y.-H.; Ismadji, S. Nanocelluloses: Sources, pretreatment, isolations, modification, and its application as the drug carriers. Polymers 2021, 13, 2052. [Google Scholar] [CrossRef]
- Ullah, H.; Santos, H.A.; Khan, T. Applications of bacterial cellulose in food, cosmetics and drug delivery. Cellulose 2016, 23, 2291–2314. [Google Scholar] [CrossRef]
- Shi, Z.; Zhang, Y.; Phillips, G.O.; Yang, G. Utilization of bacterial cellulose in food. Food Hydrocoll. 2014, 35, 539–545. [Google Scholar] [CrossRef]
- Fernandes, M.; Gama, M.; Dourado, F.; Souto, A. Development of novel bacterial cellulose composites for the textile and shoe industry. Microb. Biotechnol. 2019, 12, 650–661. [Google Scholar] [CrossRef] [Green Version]
- Albuquerque, P.B.S.; Oliveira, W.F.; Santos Silva, P.M.; Santos Correia, M.T.; Kennedy, J.F.; Barroso Coelho, L.C.B. Epiphanies of well-known and newly discovered macromolecular carbohydrates—A review. Int. J. Biol. Macromol. 2020, 156, 51–66. [Google Scholar] [CrossRef]
- Velasquez-Riano, M.; Bojaca, V. Production of bacterial cellulose from alternative low-cost substrates. Cellulos 2017, 24, 2677–2698. [Google Scholar] [CrossRef]
- Hestrin, S.; Schramm, M. Synthesis of cellulose by Acetobacter xylinum. 2. Preparation of freeze-dried cells capable of polymerizing glucose to cellulose. Biochem. J. 1954, 58, 345–352. [Google Scholar] [CrossRef] [PubMed] [Green Version]
- Volova, T.G.; Prudnikova, S.V.; Shishatskaya, E.I. Bacterial strain Komagataeibacter xylinus—Bacterial Cellulose Producer. RF Patent RU 2568605 C1, 20 November 2015. (In Russian). [Google Scholar]
- Volova, T.G.; Prudnikova, S.V.; Sukovatyi, A.G.; Shishatskaya, E.I. Production and properties of bacterial cellulose by the strain Komagataeibacter xylinus B-12068. Appl. Microbiol. Biotechnol. 2018, 102, 7417–7428. [Google Scholar] [CrossRef] [PubMed] [Green Version]
- Volova, T.; Sapozhnikova, K.; Zhila, N. Cupriavidus necator B-10646 growth and polyhydroxyalkanoates production on different plant oils. Int. J. Biol. Macromol. 2020, 164, 121–130. [Google Scholar] [CrossRef] [PubMed]
- Yang, G.; Xie, J.; Deng, Y.; Bian, Y.; Hong, F. Hydrothermal synthesis of bacterial cellulose/AgNPs composite: A “green” route for antibacterial application. Carbohydr. Polym. 2012, 87, 2482–2487. [Google Scholar] [CrossRef]
- Park, J.K.; Jung, J.Y.; Park, Y.H. Cellulose production by Gluconacetobacter hansenii in a medium containing ethanol. Biotechnol. Lett. 2003, 25, 2055–2059. [Google Scholar] [CrossRef]
- Dayal, M.S.; Goswami, N.; Sahai, A.; Jain, V.; Mathur, G.; Mathur, A. Effect of media components on cell growth and bacterial cellulose production from Acetobacter aceti MTCC 2623. Carbohydr. Polym. 2013, 94, 12–16. [Google Scholar] [CrossRef] [PubMed]
- Keshk, S.M. Bacterial cellulose production and its industrial applications. J. Bioprocess Biotech. 2014, 4, 150. [Google Scholar] [CrossRef]
- Mohammadkazemi, F.; Azin, M.; Ashori, A. Production of bacterial cellulose using different carbon sources and culture media. Carbohydr. Polym. 2015, 117, 518–523. [Google Scholar] [CrossRef] [PubMed]
- Pokalwar, S.U.; Mishra, M.K.; Manwar, A.V. Production of cellulose by Gluconacetobacter sp. Recent Res. Sci. Technol. 2010, 2, 14–19. [Google Scholar]
- Ruka, D.R.; Simon, G.P.; Dean, K.M. Altering the growth conditions of Gluconacetobacter xylinus to maximize the yield of bacterial cellulose. Carbohydr. Polym. 2012, 89, 613–622. [Google Scholar] [CrossRef]
- Li, Z.; Wang, L.; Hua, J.; Jia, S.; Zhang, J.; Liu, H. Production of nano bacterial cellulose from waste water of candied jujube-processing industry using Acetobacter xylinum. Carbohydr. Polym. 2015, 120, 115–119. [Google Scholar] [CrossRef] [PubMed]
- Çakar, F.; Özer, I.; Aytekin, A.Ö.; Sahin, F. Improvement production of bacterial cellulose by semi-continuous process in molasses medium. Carbohydr. Polym. 2014, 106, 7–13. [Google Scholar] [CrossRef]
- Jung, J.Y.; Park, J.K.; Chang, H.N. Bacterial cellulose production by Gluconacetobacter hansenii in an agitated culture without living non-cellulose producing cells. Enzyme Microb. Technol. 2005, 37, 347–354. [Google Scholar] [CrossRef]
- Reiniati, I.; Hrymak, A.N.; Margaritis, A. Recent developments in the production and applications of bacterial cellulose fibers and nanocrystals. Crit. Rev. Biotechnol. 2016, 36, 510–524. [Google Scholar] [CrossRef]
- Yassine, F.; Bassil, N.; Flouty, R.; Chokr, A.; Samrani, A.E.; Boiteux, G.; Tahchi, M.E. Culture medium pH influence on Gluconacetobacter physiology: Cellulose production rate and yield enhancement in presence of multiple carbon sources. Carbohydr. Polym. 2016, 146, 282–291. [Google Scholar] [CrossRef]
- McNamara, J.T.; Morgan, J.L.; Zimmer, J. A molecular description of cellulose biosynthesis. Annu. Rev. Biochem. 2015, 84, 895–921. [Google Scholar] [CrossRef] [PubMed] [Green Version]
- Schramm, M.; Hestrin, S. Factors affecting production of cellulose at the air/liquid interface of a culture of Acetobacter xylinum. Microbiology 1954, 11, 123–129. [Google Scholar] [CrossRef] [PubMed] [Green Version]
- Jung, H.; Jeong, J.; Lee, O.; Park, G.T.; Kim, K.K.; Park, H.C.; Lee, S.M.; Kim, Y.G.; Son, H.J. Influence of glycerol on production and structural-physical properties of cellulose from Acetobacter sp. V6 cultured in shake flasks. Biores. Technol. 2010, 101, 3602–3608. [Google Scholar] [CrossRef] [PubMed]
- Keshk, S.; Sameshima, K. The utilization of sugar cane molasses with/without the presence of lignosulfonate for the production of bacterial cellulose. Appl. Microbiol. Biotechnol. 2006, 72, 291–296. [Google Scholar] [CrossRef]
- Tyagi, N.; Suresh, S. Production of cellulose from sugarcane molasses using Gluconacetobacter intermedius SNT-1: Optimization & characterization. J. Clean. Prod. 2016, 112, 71–80. [Google Scholar] [CrossRef]
- Aytekin, A.Ö.; Demirbağ, D.D.; Bayrakdar, T. The statistical optimization of bacterial cellulose production via semi-continuous operation mode. J. Ind. Eng. Chem. 2016, 37, 243–250. [Google Scholar] [CrossRef]
- Yang, X.Y.; Huang, C.; Guo, H.J.; Xiong, L.; Luo, J.; Wang, B.; Lin, X.Q.; Chen, X.F.; Chen, X.D. Bacterial cellulose production from the litchi extract by Gluconacetobacter xylinus. Prep. Biochem. Biotechnol. 2016, 46, 39–43. [Google Scholar] [CrossRef] [PubMed]
- Huang, C.; Guo, H.J.; Xiong, L.; Wang, B.; Shi, S.L.; Chen, X.F.; Lin, X.Q.; Wang, C.; Luo, J.; Chen, X.D. Using wastewater after lipid fermentation as substrate for bacterial cellulose production by Gluconacetobacter xylinus. Carbohydr. Polym. 2016, 136, 198–202. [Google Scholar] [CrossRef] [PubMed]
- Revin, V.V.; Klenova, N.A.; Redkin, N.A.; Belousova, Z.P.; Tukmakov, K.N.; Markova, Y.A.; Sosova, E.Y. Production and studying properties of composites based on bacterial cellulose and poly-N,N-dimethyl-3,4-methylenpirrolidine chloride. Izvestiya Vuzov. Prikl. Khimiya Biotekhnolog. 2017, 7, 102–110. [Google Scholar] [CrossRef]
- Skiba, E.A.; Gladysheva, E.K.; Golubev, D.S.; Budaeva, V.V.; Aleshina, L.A.; Sakovich, G.V. Self-standardization of quality of bacterial cellulose produced by Medusomyces gisevii in nutrient media derived from Miscanthus biomass. Carbohydr. Polym. 2021, 252, 117178. [Google Scholar] [CrossRef] [PubMed]
- Revin, V.; Pestov, N.; Shchankin, M.; Mishkin, V.; Platonov, V.; Uglanov, D. A study of the physical and mechanical properties of aerogels obtained from bacterial cellulose. Biomacromolecules 2019, 20, 1401–1411. [Google Scholar] [CrossRef] [PubMed]
- Czaja, W.; Romanovicz, D.; Brown, R. Structural investigations of microbial cellulose produced in stationary and agitated culture. Cellulose 2004, 11, 403–411. [Google Scholar] [CrossRef]
- Castro, C.; Zuluaga, R.; Putaux, J.L.; Caro, G.; Mondragon, I.; Ganan, P. Structural characterization of bacterial cellulose produced by Gluconacetobacter swingsii sp. from Colombian agroindustrial wastes. Carbohydr. Polym. 2011, 84, 96–102. [Google Scholar] [CrossRef]
- French, A.D. Idealized powder diffraction patterns for cellulose polymorphs. Cellulose 2014, 21, 885–896. [Google Scholar] [CrossRef]
- Barud, H.S.; Ribeiro, C.A.; Crespi, M.S.; Martines, M.A.U.; Dexpert-Ghys, J.; Marques, R.F.C.; Ribeiro, S.J.L. Thermal characterization of bacterial cellulose—Phosphate composite membranes. J. Therm. Anal. Calorim. 2007, 87, 815–818. [Google Scholar] [CrossRef]
- Feng, Y.; Zhang, X.; Shen, Y.; Yoshino, K.; Feng, W. A mechanically strong, flexible and conductive film based on bacterial cellulose/graphene nanocomposite. Carbohydr. Polym. 2012, 87, 644–649. [Google Scholar] [CrossRef] [PubMed]
- Volova, T.G.; Shumilova, A.A.; Shidlovskiy, I.P.; Nikolaeva, E.D.; Sukovatiy, A.G.; Vasiliev, A.D.; Shishatskaya, E.I. Antibacterial properties of films of cellulose composites with silver nanoparticles and antibiotics. Polym. Test. 2018, 65, 54–68. [Google Scholar] [CrossRef] [Green Version]
- Gupta, A.; Briffa, S.M.; Swingler, S.; Gibson, H.; Kannappan, V.; Adamus, G.; Kowalczuk, M.; Martin, C.; Radecka, I. Synthesis of silver nanoparticles using curcumin-cyclodextrins loaded into bacterial cellulose-based hydrogels forwound dressing applications. Biomacromolecules 2020, 21, 1802–1811. [Google Scholar] [CrossRef] [PubMed]
- Melnikova, N.; Knyazev, A.; Nikolskiy, V.; Peretyagin, P.; Belyaeva, K.; Nazarova, N.; Liyaskina, E.; Malygina, D.; Revin, V. Wound healing composite materials of bacterial cellulose and zinc oxide nanoparticles with immobilized betulin diphosphate. Nanomaterials 2021, 11, 713. [Google Scholar] [CrossRef] [PubMed]
- Bhattacharya, A.; Sadaf, A.; Dubey, S.; Singh, R.P.; Khare, S.K. Production and characterization of Komagataeibacter xylinus SGP8 nanocellulose and its calcite based composite for removal of Cd ions. Environ. Sci. Pollut. Res. 2021, 28, 46423–46430. [Google Scholar] [CrossRef] [PubMed]
- Sureshkumar, M.; Siswanto, D.Y.; Lee, C.K. Magnetic antimicrobial nanocomposite based on bacterial cellulose and silver nanoparticles. J. Mater. Chem. 2010, 20, 6948–6955. [Google Scholar] [CrossRef]
- Feng, J.; Shi, Q.; Li, W.; Shu, X.; Chen, A.; Xie, X.; Huang, X. Antimicrobial activity of silver nanoparticles in situ growth on TEMPO-mediated oxidized bacterial cellulose. Cellulose 2014, 21, 4557–4567. [Google Scholar] [CrossRef]
- Shao, W. Controlled release and antibacterial activity of tetracyclinehydrochloride-loaded bacterial cellulose composite membranes. Carbohydr. Polym. 2016, 145, 114–120. [Google Scholar] [CrossRef] [PubMed]
- Jung, R.; Kim, Y.; Kim, H.S.; Jin, H.J. Antimicrobial properties of hydrated cellulose membranes with silver nanoparticles. J. Biomater. Sci. Polym. Ed. 2009, 20, 311–324. [Google Scholar] [CrossRef]
- Yu, H.-Y.; Yang, X.-Y.; Lu, F.-F.; Chen, G.-Y.; Yao, J.-M. Fabrication of multifunctional cellulose nanocrystals/poly(lactic acid)nanocomposites with silver nanoparticles by spraying method. Carbohydr. Polym. 2016, 140, 209–219. [Google Scholar] [CrossRef]
- Zhang, Y.; Peng, H.; Huang, W.; Zhou, Y.; Yan, D. Facile preparation and characterization of highly antimicrobial colloid Ag or Au nanoparticles. J. Colloid Interface Sci. 2008, 325, 371–376. [Google Scholar] [CrossRef] [PubMed]
- Sadanand, V.; Rajini, N.; Satyanarayana, B.; Rajulu, A.V. Preparation and properties of cellulose/silver nanoparticle composites with in situ-generated silver nanoparticles using Ocimum sanctum leaf extract. Int. J. Polym. Anal. Charact. 2016, 21, 408–416. [Google Scholar] [CrossRef]
- Wan, Y.; Hu, D.; Xiong, G.; Li, D.; Guo, R.; Luo, H. Directional fluid induced selfassembly of oriented bacterial cellulose nanofibers for potential biomimetic tissue engineering scaffolds. Mater. Chem. Phys. 2015, 145, 7–11. [Google Scholar] [CrossRef]
- Muthulakshmi, L.; Rajini, N.; Nellaiah, H.; Kathiresan, T.; Jawaid, M.; Rajulu, A.V. Preparation and properties of cellulose nanocomposite films with in situ generated copper nanoparticles using Terminalia catappa leaf extract. Int. J. Biol. Macromol. 2017, 95, 1064–1071. [Google Scholar] [CrossRef] [PubMed]
- Gromovykh, T.I.; Sadykova, V.S.; Lutcenko, S.V.; Dmitrenok, A.S.; Feldman, N.B.; Danilchuk, T.N.; Kashirin, V.V. Bacterial cellulose synthesized by Gluconacetobacter hansenii for medical applications. Appl. Biochem. Microbiol. 2017, 53, 60–67. [Google Scholar] [CrossRef]
- Wei, B.; Yang, G.; Hong, F. Preparation and evaluation of a kind of bacterial cellulose dry films with antibacterial properties. Carbohydr. Polym. 2011, 84, 533–538. [Google Scholar] [CrossRef]
- Wijaya, C.J.; Saputra, S.N.; Soetaredjo, F.E.; Putro, J.N.; Lin, C.X.; Kurniawan, A.; Ju, Y.H.; Ismadji, S. Cellulose nanocrystals from passion fruit peels waste as antibiotic drug carrier. Carbohydr. Polym. 2017, 175, 370–376. [Google Scholar] [CrossRef] [Green Version]
- Hosseini, H.; Zirakjou, A.; Goodarzi, V.; Mousavi, S.M.; Khonakdar, H.A.; Zamanlui, S. Lightweight aerogels based on bacterial cellulose/silver nanoparticles/polyaniline with tuning morphology of polyaniline and application in soft tissue engineering. Int. J. Biol. Macromol. 2020, 152, 57–67. [Google Scholar] [CrossRef]
- Yang, G.; Yao, Y.; Wang, C. Green synthesis of silver nanoparticles impregnated bacterial cellulose-alginate composite film with improved properties. Mater. Lett. 2017, 209, 11–14. [Google Scholar] [CrossRef]
- Salari, M.; Khiabani, M.S.; Mokarram, R.R.; Ghanbarzadeh, B.; Kafil, H.S. Development and evaluation of chitosan based active nanocomposite films containing bacterial cellulose nanocrystals and silver nanoparticles. Food Hydrocoll. 2018, 84, 414–423. [Google Scholar] [CrossRef]
- Quinteros, M.A.; Viviana, C.A.; Onnainty, R.; Mary, V.S.; Theumer, M.G.; Granero, G.E.; Paraje, M.G.; Páez, P.L. Biosynthesized silver nanoparticles: Decoding their mechanism of action in Staphylococcus aureus and Escherichia coli. Int. J. Biochem. Cell Biol. 2018, 104, 87–93. [Google Scholar] [CrossRef] [Green Version]
- Panáček, A.; Kvítek, L.; Smékalová, M.; Večeřová, R.; Kolář, M.; Röderová, M.; Zbořil, R. Bacterial resistance to silver nanoparticles and how to overcome it. Nat. Nanotechnol. 2018, 13, 65–71. [Google Scholar] [CrossRef] [PubMed]
- Pazos-Ortiz, E.; Roque-Ruiz, J.H.; Hinojos-Márquez, E.A.; López-Esparza, J.; Donohué-Cornejo, A.; Cuevas-González, J.C.; Espinosa-Cristóbal, L.F.; Reyes-López, S.Y. Dose-dependent antimicrobial activity of silver nanoparticles on polycaprolactone fibers against gram-positive and gram-negative bacteria. J. Nanomater. 2017, 2017, 4752314. [Google Scholar] [CrossRef] [Green Version]
- Li, W.R.; Xie, X.B.; Shi, Q.S.; Zeng, H.Y.; You-Sheng, O.Y.; Chen, Y.B. Antibacterial activity and mechanism of silver nanoparticles on Escherichia coli. Appl. Microbiol. Biotechnol. 2010, 85, 1115–1122. [Google Scholar] [CrossRef] [PubMed]
- Durán, N.; Durán, M.; De Jesus, M.B.; Seabra, A.B.; Fávaro, W.J.; Nakazato, G. Silver nanoparticles: A new view on mechanistic aspects on antimicrobial activity. Nanomedicine 2016, 12, 789–799. [Google Scholar] [CrossRef]
- Giao, N.T.; Limpiyakorn, T.; Kunapongkiti, P.; Thuptimdang, P.; Siripattanakul-Ratpukdi, S. Influence of silver nanoparticles and liberated silver ions on nitrifying sludge: Ammonia oxidation inhibitory kinetics and mechanism. Environ. Sci. Pollut. Res. 2017, 24, 9229–9240. [Google Scholar] [CrossRef] [PubMed]
- Liyaskina, E.; Revin, V.; Paramonova, E.; Nazarkina, M.; Pestov, N.; Revina, N.; Kolesnikova, S. Nanomaterials from bacterial cellulose for antimicrobial wound dressing. In Journal of Physics: Conference Series, Proceedings of the 1st International Symposium ‘Physics, Engineering and Technologies for Bio-Medicine, Moscow, Russia, 18–23 October 2016; IOP Publishing: Bristol, UK, 2017; Volume 784, p. 010234. [Google Scholar] [CrossRef] [Green Version]
- Tamahkar, E.; Bakhshpour, M.; Denizli, A. Molecularly imprinted composite bacterial cellulose nanofibers for antibiotic release. J. Biomater. Sci. Polym. Ed. 2019, 30, 450–461. [Google Scholar] [CrossRef]

| C-Substrate | Yield BC, g/L | Productivity, g/L·Day−1 |
|---|---|---|
| Glucose | 3.22 ± 0.37 | 0.64 |
| Glucose + sunflower oil | 2.21 ± 0.49 | 0.44 |
| Molasses | 3.34 ± 0.30 | 0.67 |
| Glycerol | 3.90 ± 0.30 | 0.78 |
| Sprat oil | 3.23 ± 0.43 | 0.65 |
| Parameters | Yield of BC, g/L | Productivity, g/L·Day−1 |
|---|---|---|
| Mixer revolutions, rpm | ||
| 50 | 0.53 | 0.08 |
| 250 | 0.71 | 0.10 |
| 500 | 2.67 | 0.38 |
| 750 | 1.40 | 0.20 |
| Air supply, L/min per L of the medium (at 500 rpm of the mixer) | ||
| 0.3 | 2.92 | 0.42 |
| 0.4 | 3.33 | 0.48 |
| 0.6 | 2.15 | 0.31 |
| Samples | Physical-Mechanical Properties | Surface Properties | ||||
|---|---|---|---|---|---|---|
| Young’s Modulus [MPa] | Tensile Strength [MPa] | Elongation at Break [%] | Water Contact Angle [°] | Dispersive Component [mN/m] | Polar Component [mN/m] | |
| BC native, wet (moisture content 90%) | 10.2 ± 1.3 | 0.7 ± 0.3 | 5.5 ± 1.2 | 41.9 ± 3.4 | 44.8 ± 1.5 | 20.9 ± 0.7 |
| BC dry (moisture content 50–55%) | 47.6 ± 6.3 | 0.1 ± 0.1 | 4.4 ± 0.8 | 48.2 ± 6.7 | 46.6 ± 0.6 | 16.8 ± 0.6 |
| BC/AgNPs (moisture content 50–55%) | ||||||
| BC/AgNPs 0.10 g/L | 233.0 ± 5.2 | 14.9 ± 1.7 | 9.8 ± 2.6 | 50.3 ± 4.6 | 42.6 ± 1.0 | 27.7 ± 3.6 |
| BC/AgNPs 0.05 g/L | 218.0 ± 2.2 | 13.2 ± 2.1 | 7.7 ± 2.5 | 68.8 ± 1.8 | 46.2 ± 2.9 | 22.6 ± 0.8 |
| BC/AgNPs 0.01 g/L | 99.3 ± 5.2 | 9.9 ± 1.3 | 11.7 ± 1.6 | 69.0 ± 2.7 | 44.9 ± 1.8 | 25.1 ± 0.9 |
| BC/drugs (moisture content 50–55%) | ||||||
| BC/chlorhexidine | 63.2 ± 1.8 | 6.1 ± 1.8 | 11.7 ± 2.1 | 70.4 ± 3.1 | 45.7 ± 3.1 | 24.7 ± 1.1 |
| BC/baneocin | 58.9 ± 6.9 | 5.3 ± 0.9 | 11.9 ± 2.7 | 70.2 ± 6.4 | 44.3 ± 2.9 | 25.7 ± 1.2 |
| BC/cefotaxime | 44.6 ± 4.2 | 6.4 ± 0.4 | 17.6 ± 1.1 | 68.4 ± 5.1 | 42.5 ± 2.1 | 24.2 ± 2.2 |
| BC/doripenem | 45.5 ± 8.1 | 6.0 ± 1.1 | 16.3 ± 2.5 | 72.4 ± 6.3 | 47.3 ± 3.1 | 23.2 ± 1.1 |
| Samples | Average Atomic Number (wt.%) | Ag Content (mg/cm2) | ||
| O | C | Ag | ||
| Initial BC | 60 | 41 | - | |
| Concentration of AgNO3 (g/L) | ||||
| 0.01 | 54 | 46 | 2 | 0.06 |
| 0.05 | 56 | 43 | 5 | 0.21 |
| 0.10 | 53 | 41 | 10 | 0.46 |
| Samples | Diameter of Inhibition Zones (mm) | |
|---|---|---|
| E. coli | S. aureus | |
| Boiling BC in AgNO3 solution | ||
| 0.10 g/L | 15.9 ± 0.9 | 8.7 ± 0.2 |
| 0.05 g/L | 10.8 ± 0.6 | 0 |
| 0.01 g/L | 9.3 ± 0.5 | 0 |
| Immersion of BC in AgNO3 solution for 9 days | ||
| 0.10 g/L | 21.1 ± 1.2 | 8.7 ± 0.5 |
| 0.05 g/L | 12.1 ± 0.7 | 0 |
| 0.01 g/L | 11.4 ± 0.7 | 0 |
| Immersion of BC in 0.05% water solution of drags | ||
| BC + chlorhexidine | 19.2 ± 1.1 | 22.8 ± 1.3 |
| BC + baneocin | 26.7 ± 1.5 | 14.0 ± 0.8 |
| BC + cefotaxime | 42.1 ± 2.2 | 26.6 ± 1.4 |
| BC + doripenem | 44.9 ± 2.0 | 42.9 ± 2.3 |
Publisher’s Note: MDPI stays neutral with regard to jurisdictional claims in published maps and institutional affiliations. |
© 2022 by the authors. Licensee MDPI, Basel, Switzerland. This article is an open access article distributed under the terms and conditions of the Creative Commons Attribution (CC BY) license (https://creativecommons.org/licenses/by/4.0/).
Share and Cite
Volova, T.G.; Prudnikova, S.V.; Kiselev, E.G.; Nemtsev, I.V.; Vasiliev, A.D.; Kuzmin, A.P.; Shishatskaya, E.I. Bacterial Cellulose (BC) and BC Composites: Production and Properties. Nanomaterials 2022, 12, 192. https://doi.org/10.3390/nano12020192
Volova TG, Prudnikova SV, Kiselev EG, Nemtsev IV, Vasiliev AD, Kuzmin AP, Shishatskaya EI. Bacterial Cellulose (BC) and BC Composites: Production and Properties. Nanomaterials. 2022; 12(2):192. https://doi.org/10.3390/nano12020192
Chicago/Turabian StyleVolova, Tatiana G., Svetlana V. Prudnikova, Evgeniy G. Kiselev, Ivan V. Nemtsev, Alexander D. Vasiliev, Andrey P. Kuzmin, and Ekaterina I. Shishatskaya. 2022. "Bacterial Cellulose (BC) and BC Composites: Production and Properties" Nanomaterials 12, no. 2: 192. https://doi.org/10.3390/nano12020192
APA StyleVolova, T. G., Prudnikova, S. V., Kiselev, E. G., Nemtsev, I. V., Vasiliev, A. D., Kuzmin, A. P., & Shishatskaya, E. I. (2022). Bacterial Cellulose (BC) and BC Composites: Production and Properties. Nanomaterials, 12(2), 192. https://doi.org/10.3390/nano12020192

